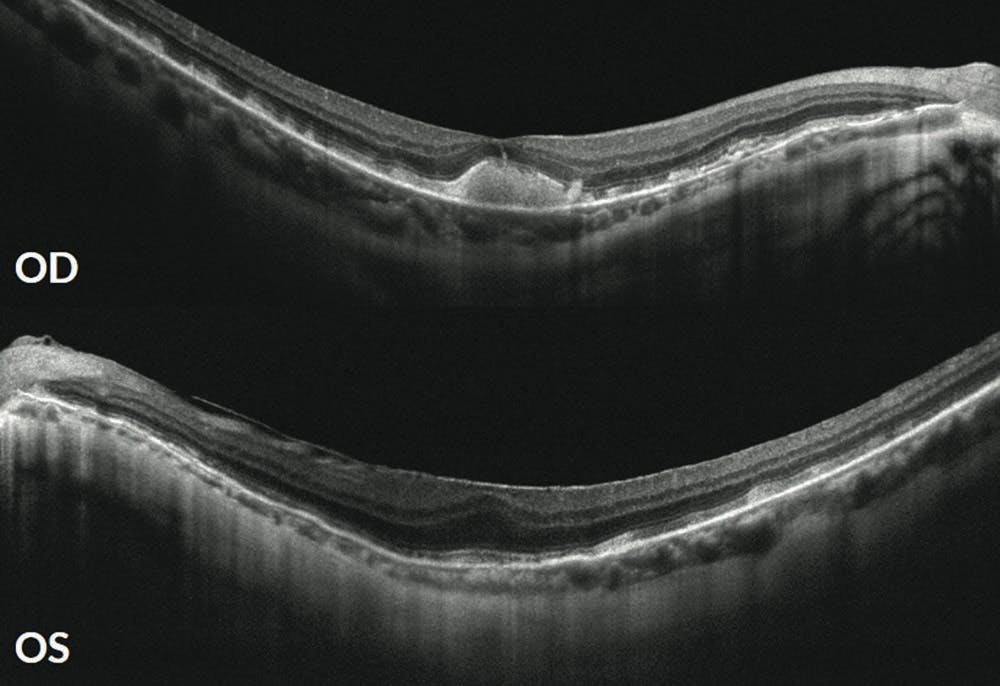
<p>Figure 1. SD-OCT of a 55-year-old patient with intermediate AMD reveals bilateral SDDs with few soft drusen. Subfoveal choroidal thickness was reduced at 159 μm OD and 99 μm OS. A pseudovitelliform macular lesion is also noted in the right eye. Subsequent cardiovascular and neurovascular workup revealed 40% internal carotid stenosis bilaterally.</p>

Researchers have been exploring the association between cardiovascular disease and AMD for decades. Our team at the New York Eye and Ear Infirmary (NYEE) of Mount Sinai recently found that patients with a specific form of AMD with subretinal drusenoid deposits (SDDs) are highly likely to have either underlying heart damage from heart failure and heart attacks, advanced heart valve disease, or carotid artery disease associated with certain types of strokes.1,2
This research is the first to identify which types of high-risk vascular diseases (HRVDs) are linked to the presence of SDDs.1 The findings could prompt increased screening to save vision, help diagnose undetected heart disease, and prevent adverse events. New approaches to proper multidisciplinary screening of these chronic diseases in at-risk populations may serve to greatly reduce morbidity and mortality.
THE STUDY
Our study of 200 patients with intermediate AMD found that 85% of those with a history of myocardial infarction, heart failure, major valve disease, and/or ischemic stroke had SDDs on multimodal imaging. We found that AMD patients with these cardiovascular diseases and stroke were nine times more likely to have SDDs than those without them.1
The study suggests that SDDs are markers for a retinal disease that is distinct from soft drusen and may be driven by systemic vascular disease. Therefore, patients with SDDs (with or without soft drusen) may require more than the standard vitamin supplementation; they may need a trip to the cardiologist or neurologist for evaluation of underlying disease (Figure 1). A standard cardiovascular workup with a transthoracic echocardiogram (TTE) and computed tomography angiography (CTA) could save the patient from a life-threatening event.
Figure 1. SD-OCT of a 55-year-old patient with intermediate AMD reveals bilateral SDDs with few soft drusen. Subfoveal choroidal thickness was reduced at 159 μm OD and 99 μm OS. A pseudovitelliform macular lesion is also noted in the right eye. Subsequent cardiovascular and neurovascular workup revealed 40% internal carotid stenosis bilaterally.
UNDERSTANDING THE PARADIGM
The retina, especially its photoreceptors, consumes oxygen more rapidly than any other tissue in the human body. This photoreceptor layer is where SDDs are found, and its blood supply from the choroid may give a clue to the pathophysiology. The choroid is an end-arterial system (without adjacent anastomosis) that provides the greatest blood flow per unit mass and, unlike the retinal circulation, does not derive protection by autoregulation. Thus, the literature has confirmed generalized choroidal thinning in the setting of coronary artery disease (CAD).
In another study conducted at NYEE, 38 subjects with CAD and no known retinal disease were imaged with near-infrared reflectance and spectral-domain (SD) OCT for the presence of SDDs.3 SDDs were significantly more frequent (relative risk = 2.1) in subjects with CAD versus those without, with no association seen between CAD and soft drusen.
We hypothesized a straightforward vascular mechanism for the association: The blood supply to the eye is directly diminished by these diseases, either by heart damage that diminishes systemic blood supply or from a blocked carotid artery that directly impedes blood flow to the eye. A poor blood supply can cause damage to any part of the body, which manifests as SDDs in the retina. We concluded that SDDs are the result of when an already under-supported choroidal perfusion cannot compensate for a reduction in arterial blood supply (eg, CAD or other HRVDs).3
A CLOSER LOOK
We investigated further and recruited 86 patients from the inpatient stroke and cardiac units at Mount Sinai Hospital for a cross-sectional study. We found that SDDs, as imaged by SD-OCT, are present in 26% (8/31) of stroke patients and 33% (18/55) of cardiac patients.4 This initial finding confirms the Alabama Study of Early Age-Related Macular Degeneration (ALSTAR) finding of SDDs in approximately 25% of older adults.5 SDDs are strongly associated with AMD severity and progression. In the same ALSTAR study, SDDs were present in 49% of early AMD and 79% of intermediate AMD patients.
Findings from the same preliminary data of 86 inpatients corroborate the association between HRVD and SDDs. SDDs showed a significant correlation with both internal carotid artery stenosis by CTA and cardiac index calculated from TTE. Thus, SDDs may be the lynchpin that connects ophthalmology, cardiology, and neurology when caring for these patients (Figure 2).

Figure 2. This diagram shows the pathways by which a singular diagnosis can lead to multidisciplinary care. Genetic workup, specifically for homozygous ARMS2 mutation, is another way to identify an at-risk population for SDD-subtype AMD.6
FUTURE PLANS
While this data suggest the utility of screening for SDDs in at-risk patient populations, the relationship between AMD and vascular disease has never been fully evaluated. The exact parameters and cutoff needed for adequate noninvasive and cost-effective screening remain under investigation. We continue to question whether SD-OCT is the best imaging modality for SDD detection. While it has frequently been used as the standard for evaluating AMD, SD-OCT image capture and analysis require trained individuals.
We partnered with iHealthScreen to develop automated artificial intelligence (AI)-based AMD screening and prediction tools based on color fundus photographs.7 An embossed photo technique—in which each pixel was replaced by a highlight or a shadow depending on light and dark boundaries present in the original fundus photographs—showed a high sensitivity for detecting SDDs compared with multimodal image analysis.8 Preliminary data on 1,115 color fundus photographs obtained for the AI-based AMD screening compared with SD-OCT showed > 90% positive and negative predictive values.9 Through this new embossed photo technique, screening for SDD in clinical practice could become AI-automated.9
We now know that SDDs are strongly associated with vascular disorders, and they may one day be widely recognized as a biomarker of cardiovascular and neurovascular compromise, allowing for effective referral to specialists and prevention of death and blindness.
1. Ledesma-Gil G, Otero-Marquez O, Alauddin S, et al. Subretinal drusenoid deposits are strongly associated with coexistent high-risk vascular diseases. BMJ Open Ophthalmol. 2022;7:e001154.
2. Study: form of AMD strongly associated with cardiovascular disease [press release]. November 21, 2022. Accessed April 28, 2023. eyewire.news/news/study-blinding-eye-disease-strongly-associated-with-serious-forms-of-cardiovascular-disease
3. Cymerman RM, Skolnick AH, Cole WJ, Nabati C, Curcio CA, Smith RT. Coronary artery disease and reticular macular disease, a subphenotype of early age-related macular degeneration. Curr Eye Res. 2016;41(11):1482-1488.
4. Mordechaev E, Fei Y, Le B, Lema G, Rosen RB, Smith RT. Age-related macular degeneration (AMD) and systemic vascular disease. Poster presented at ARVO; April 25, 2023; New Orleans.
5. Zarubina AV, Neely DC, Clark ME, et al. Prevalence of subretinal drusenoid deposits in older persons with and without age-related macular degeneration, by multimodal imaging. Ophthalmology. 2016;123(5):1090-1100.
6. Chazaro J, Thomson T, Coughlin A, et al. Comparing phenotype of subretinal drusenoid deposits in age related macular degeneration (AMD) with ARMS2 risk alleles versus high risk vascular disease. Invest Ophthalmol Vis Sci. 2022;63(7):371-F0202.
7. Bhuiyan A, Govindaiah A, Alauddin S, Otero-Marquez O, Smith RT. Combined automated screening for age-related macular degeneration and diabetic retinopathy in primary care settings. Ann Eye Sci. 2021;6:12.
8. Kadomoto S, Nanegrungsunk O, Nittala MG, Karamat A, Sadda SR. Enhanced detection of reticular pseudodrusen on color fundus photos by image embossing. Curr Eye Res. 2022;47(11):1547-1552.
9. Fei Y, Kadamoto S, Mordechaev E, et al. Validation of embossing technique for subretinal drusenoid deposits on color fundus photos. Poster presented at ARVO; April 24, 2023; New Orleans.
























